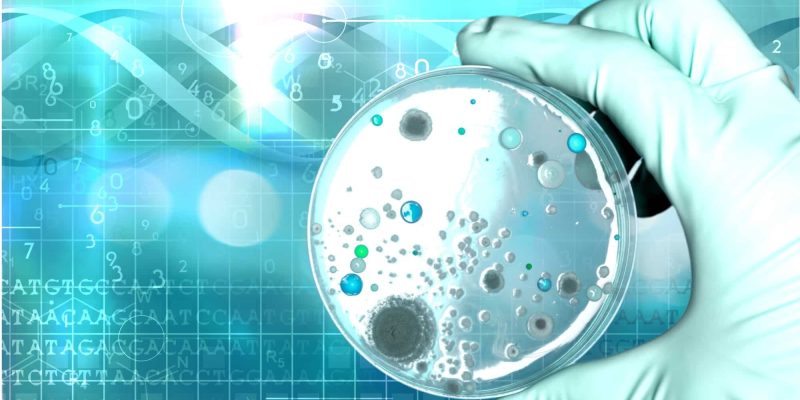
Effektive Mikroorganismen für den Körper

Die vegane Ernährung erfreut sich in letzter Zeit einer immer größer werdenden Fan Gemeinde. Veganer aus Überzeugung zu sein heißt gesund leben und auch den Tieren kein Unheil mehr anzutun! Auch wenn man als Veganer mit vielen Vorurteilen zu kämpfen hat, entscheiden sich doch immer mehr Menschen ...
READ MORE +